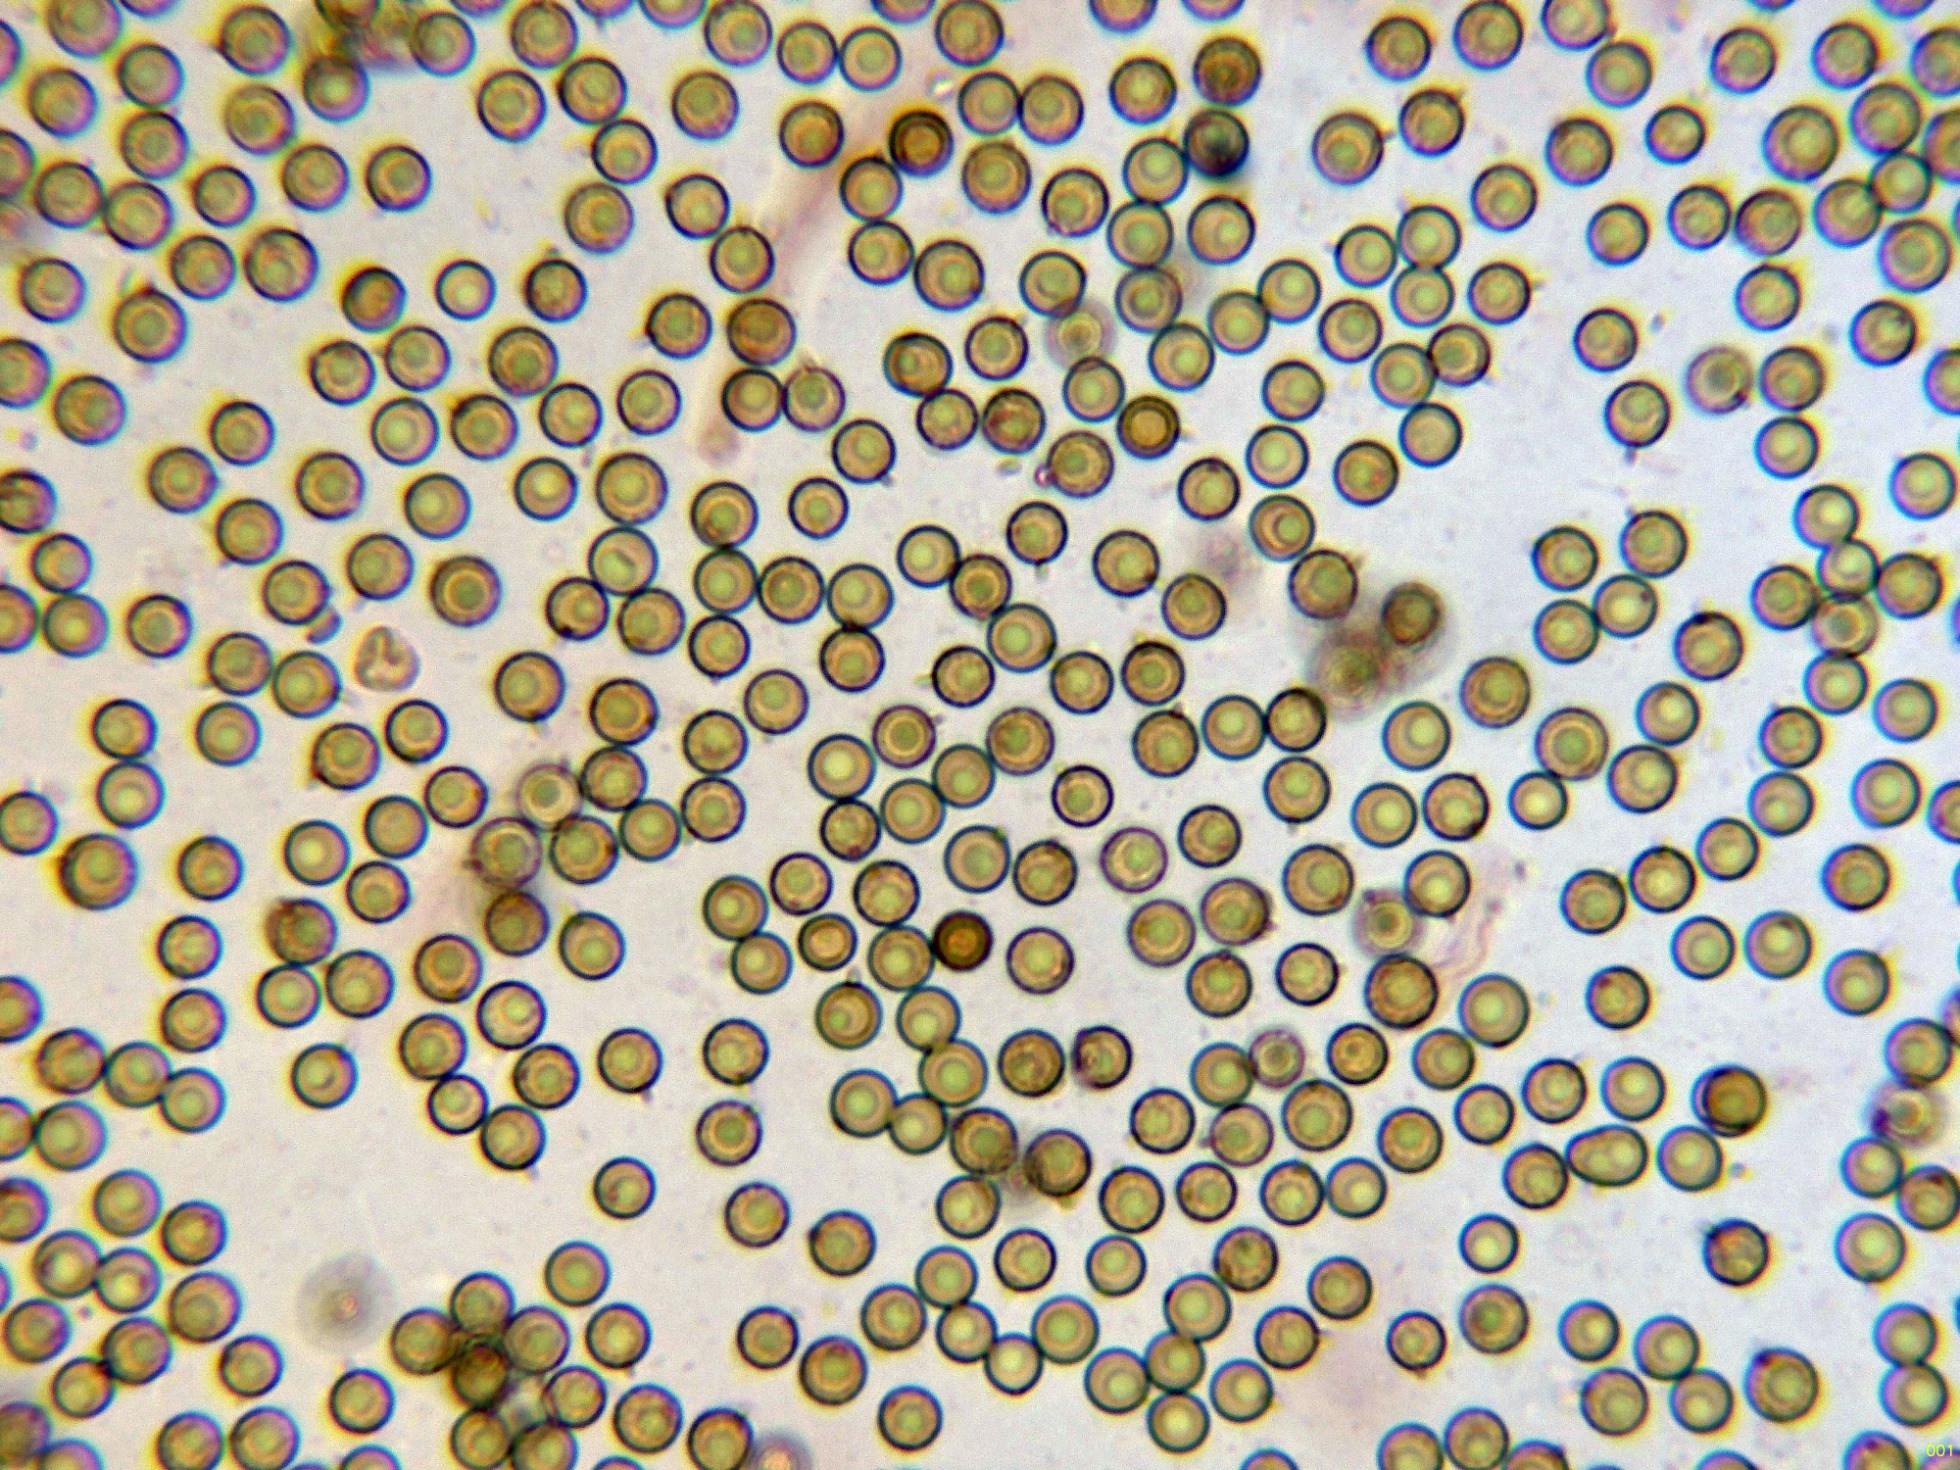

Fungimasters 2024: El resto
Fungimasters 2024: El resto
- Josep Torres
-
 Autor del tema
Autor del tema
- Ausente
- Moderador
-

Menos
Más
- Mensajes: 8746
- Gracias recibidas: 8379
1 año 4 meses antes - 1 año 4 meses antes #110342
por Josep Torres
Fungimasters 2024: El resto Publicado por Josep Torres
Hola.
El resto de lo que dio de si la jornada con los Fungimasters, a falta de un par de especies pendientes de análisis molecular.
Un Inocybe propio de pinares, con caulocistidios solo en la parte alta del pie, con sombrero mamelonado, la Inocybe fuscidula.
Las hifas de la suprapellis en agua:
Una imágen con la anchura de estas hifas:
Caulocistidios con cristalizaciones presentes en la parte alta del pie:
Hifas de la parte media del pie, sin caulocistidios:
Queilocistidios con cristalizaciones, con unas medidas de (44.2) 49.5 - 54.5 (55) × (14) 14.8 - 18.7 (19.8) µm.
Pleurocistidios dispersos con una morfología parecida a los queilocistidios:
Los basidios tetraspóricos:
Y las esporas en agua:
Estas esporas obtenidas por esporulación natural y en agua con unas medidas de:
(7.5) 8.1 - 9.8 (10.5) × (4.8) 5.1 - 5.8 (6.2) µm
Q = (1.4) 1.5 - 1.8 (1.9) ; N = 30
Me = 9 × 5.5 µm ; Qe = 1.6
Un Lycoperdon, con aguijones agrupados en forma de pirámide que al desprenderse dejan entrever una retícula, el Lycoperdon foetidum, actualmente Lycoperdon nigrescens.
Los aguijones del peridio:
Retícula que queda al desprenderse los aguijones:
Los hilos del capilicio:
Capilicio y un par de basidios:
Y las esporas:
Estas esporas con unas medidas de:
(3.7) 4.2 - 4.8 (5) × (3.4) 4 - 4.6 (4.8) µm
Q = 1 - 1.08 (1.1) ; N = 30
Me = 4.4 × 4.3 µm ; Qe = 1
Un Pluteus, que a pesar de estar contaminado por bacterias, teniendo en cuenta su arista laminar que parece coloreada y sus queilocistidios con 3 cuernos, todo apunta al Pluteus tricuspidatus, actualmente Pluteus atromarginatus.
Una ampliación de la arista laminar:
La suprapellis con pileocistidios pigmentados:
Unos pileocistidios con sus medidas:
Los pleurocistidios:
Unos pleurocistidios con sus medidas:
Y un par de imágenes de las esporas libres:
Estas esporas libres con unas medidas de:
(6.4) 6.7 - 7.5 (7.9) × (4.6) 4.7 - 5.5 (6) µm
Q = (1.2) 1.3 - 1.5 (1.6) ; N = 36
Me = 7.1 × 5.1 µm ; Qe = 1.4
Ya sin microscopía uno que me trajo Javi que al igual que los anteriores ya había estudiado, el Albatrellus confluens, actualmente Albatrellopsis confluens:
Y como que la jornada dio para mucho, una imágen de la suculenta cosecha para la cocina, con un edulis que medía nada más y nada menos que 28 cm., la cesta mide 26 con lo que no cabía en ella , a pesar de su tamaño se encontraba aún bastante aprovechable.
Saludos
El resto de lo que dio de si la jornada con los Fungimasters, a falta de un par de especies pendientes de análisis molecular.
Un Inocybe propio de pinares, con caulocistidios solo en la parte alta del pie, con sombrero mamelonado, la Inocybe fuscidula.
Las hifas de la suprapellis en agua:
Una imágen con la anchura de estas hifas:
Caulocistidios con cristalizaciones presentes en la parte alta del pie:
Hifas de la parte media del pie, sin caulocistidios:
Queilocistidios con cristalizaciones, con unas medidas de (44.2) 49.5 - 54.5 (55) × (14) 14.8 - 18.7 (19.8) µm.
Pleurocistidios dispersos con una morfología parecida a los queilocistidios:
Los basidios tetraspóricos:
Y las esporas en agua:
Estas esporas obtenidas por esporulación natural y en agua con unas medidas de:
(7.5) 8.1 - 9.8 (10.5) × (4.8) 5.1 - 5.8 (6.2) µm
Q = (1.4) 1.5 - 1.8 (1.9) ; N = 30
Me = 9 × 5.5 µm ; Qe = 1.6
Un Lycoperdon, con aguijones agrupados en forma de pirámide que al desprenderse dejan entrever una retícula, el Lycoperdon foetidum, actualmente Lycoperdon nigrescens.
Los aguijones del peridio:
Retícula que queda al desprenderse los aguijones:
Los hilos del capilicio:
Capilicio y un par de basidios:
Y las esporas:
Estas esporas con unas medidas de:
(3.7) 4.2 - 4.8 (5) × (3.4) 4 - 4.6 (4.8) µm
Q = 1 - 1.08 (1.1) ; N = 30
Me = 4.4 × 4.3 µm ; Qe = 1
Un Pluteus, que a pesar de estar contaminado por bacterias, teniendo en cuenta su arista laminar que parece coloreada y sus queilocistidios con 3 cuernos, todo apunta al Pluteus tricuspidatus, actualmente Pluteus atromarginatus.
Una ampliación de la arista laminar:
La suprapellis con pileocistidios pigmentados:
Unos pileocistidios con sus medidas:
Los pleurocistidios:
Unos pleurocistidios con sus medidas:
Y un par de imágenes de las esporas libres:
Estas esporas libres con unas medidas de:
(6.4) 6.7 - 7.5 (7.9) × (4.6) 4.7 - 5.5 (6) µm
Q = (1.2) 1.3 - 1.5 (1.6) ; N = 36
Me = 7.1 × 5.1 µm ; Qe = 1.4
Ya sin microscopía uno que me trajo Javi que al igual que los anteriores ya había estudiado, el Albatrellus confluens, actualmente Albatrellopsis confluens:
Y como que la jornada dio para mucho, una imágen de la suculenta cosecha para la cocina, con un edulis que medía nada más y nada menos que 28 cm., la cesta mide 26 con lo que no cabía en ella , a pesar de su tamaño se encontraba aún bastante aprovechable.
Saludos
Adjuntos:
Última Edición: 1 año 4 meses antes por Josep Torres. Razón: Editar un salto de línea
El siguiente usuario dijo gracias: Juan Andrés Román
Por favor, Identificarse para unirse a la conversación.
- Javi Calvo
-

- Fuera de línea
- Spammer
-

Menos
Más
- Mensajes: 7009
- Gracias recibidas: 2955
1 año 4 meses antes #110343
por Javi Calvo
Respuesta de Javi Calvo sobre el tema Fungimasters 2024: El resto
Un verdadero placer como siempre compartir contigo esta salida, 15 cromos nuevos a estas alturas no es mal bagaje, es una gozada ver el monte así lleno de setas ? ? , menuda rovellonada que había, por no hablar de los edulis XXL. Y los cromos que habrán quedado en el tintero, un saludo artista.
El siguiente usuario dijo gracias: Juan Andrés Román, Josep Torres
Por favor, Identificarse para unirse a la conversación.
- Josep Torres
-
 Autor del tema
Autor del tema
- Ausente
- Moderador
-

Menos
Más
- Mensajes: 8746
- Gracias recibidas: 8379
1 año 4 meses antes #110344
por Josep Torres
Respuesta de Josep Torres sobre el tema Fungimasters 2024: El resto
El siguiente usuario dijo gracias: Juan Andrés Román
Por favor, Identificarse para unirse a la conversación.
- Juan Andrés Román
-

- Fuera de línea
- Spammer
-

Menos
Más
- Mensajes: 2558
- Gracias recibidas: 2756
1 año 4 meses antes #110349
por Juan Andrés Román
Respuesta de Juan Andrés Román sobre el tema Fungimasters 2024: El resto
Buen resto de la salida, buenas micros todas las presentadas de ese día, y buen día y almuerzo que nos pegamos, todo un placer como siempre.
Un abrazo Josep,
Un abrazo Josep,
El siguiente usuario dijo gracias: Josep Torres
Por favor, Identificarse para unirse a la conversación.
- Josep Torres
-
 Autor del tema
Autor del tema
- Ausente
- Moderador
-

Menos
Más
- Mensajes: 8746
- Gracias recibidas: 8379
1 año 4 meses antes #110352
por Josep Torres
Respuesta de Josep Torres sobre el tema Fungimasters 2024: El resto
Muchas gracias a todos, un día de lo más placentero, a pesar del tute de kilómetros, bien que valió la pena.
Un abrazo a los tres.
Un abrazo a los tres.
Por favor, Identificarse para unirse a la conversación.
Tiempo de carga de la página: 0.338 segundos

Foro de micología